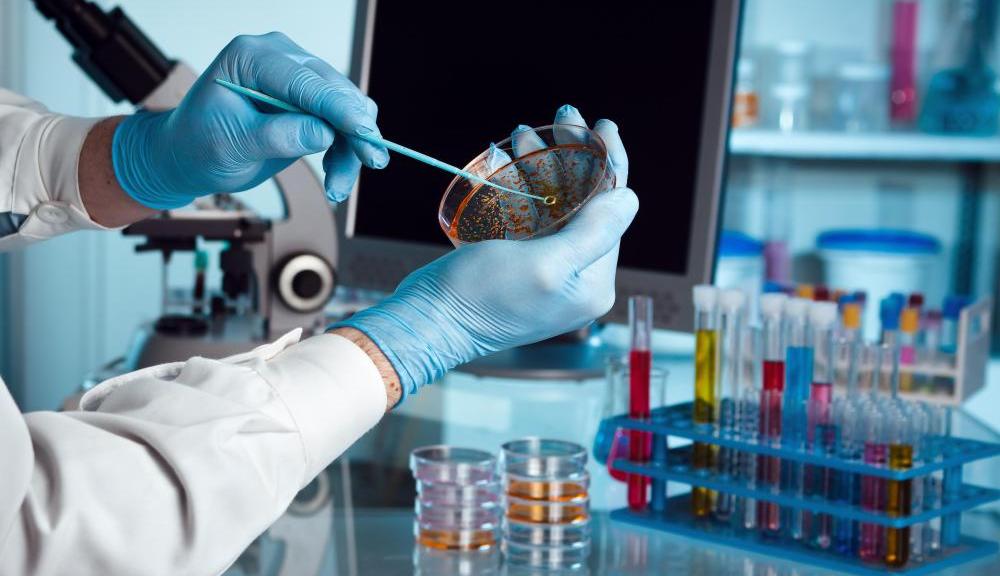
Μικροβιοκτoνια

Started March 17, 2018
0
ΜΙΚΡΟΒΙΟΚΤΟΝΙΑ
Η μικροβιοκτονία περιλαμβάνει όλες τις ενέργειες που γίνονται για την εξουδετέρωση και τον χημικό καθαρισμό ενός ευρέως φάσματος παθογόνων μικροοργανισμών από επιφάνειες και εξοπλισμό. Τέτοιοι παθογόνοι μικροοργανισμοί είναι τα βακτήρια, οι μύκητες , οι ιοί κλπ.
Η διαδικασία που ακολουθείται από την εταιρεία μας περιλαμβάνει τα εξής στάδια:
- Ενημέρωση του ιδιοκτήτη για την ανάγκη εφαρμογής μικροβιοκτονίας.
- Εκτέλεση εφαρμογής.
- Βεβαίωση μικροβιοκτονίας και ενημέρωση φακέλου μικροβιοκτονίας.
Η μικροβιοκτονία πραγματοποιείται από την BioCity είτε :
- Με ψεκασμό με χρήση νεφελοψεκαστήρα μικροβιοκτόνων σκευασμάτων ώστε να υπάρχει ομοιόμορφη και καθολική εφαρμογή του μικροβιοκτόνου σε όλη την επιφάνεια που θέλουμε να απολυμάνουμε.
- Με την χρήση ειδικής λυχνίας που εκπέμπει ακτινοβολία UVC μέσω της οποία μπορούμε να απολυμάνουμε επιφάνειες όπως πάγκους αποδυτηρίων, τροφίμων, χώρων μαζικής εστίασης κλπ.
Για την εφαρμογή της μικροβιοκτονίας χρησιμοποιούνται απολύτως ασφαλή και εγκεκριμένα σκευάσματα και όλες οι εφαρμογές πραγματοποιούνται από Γεωπόνο Π.Ε.